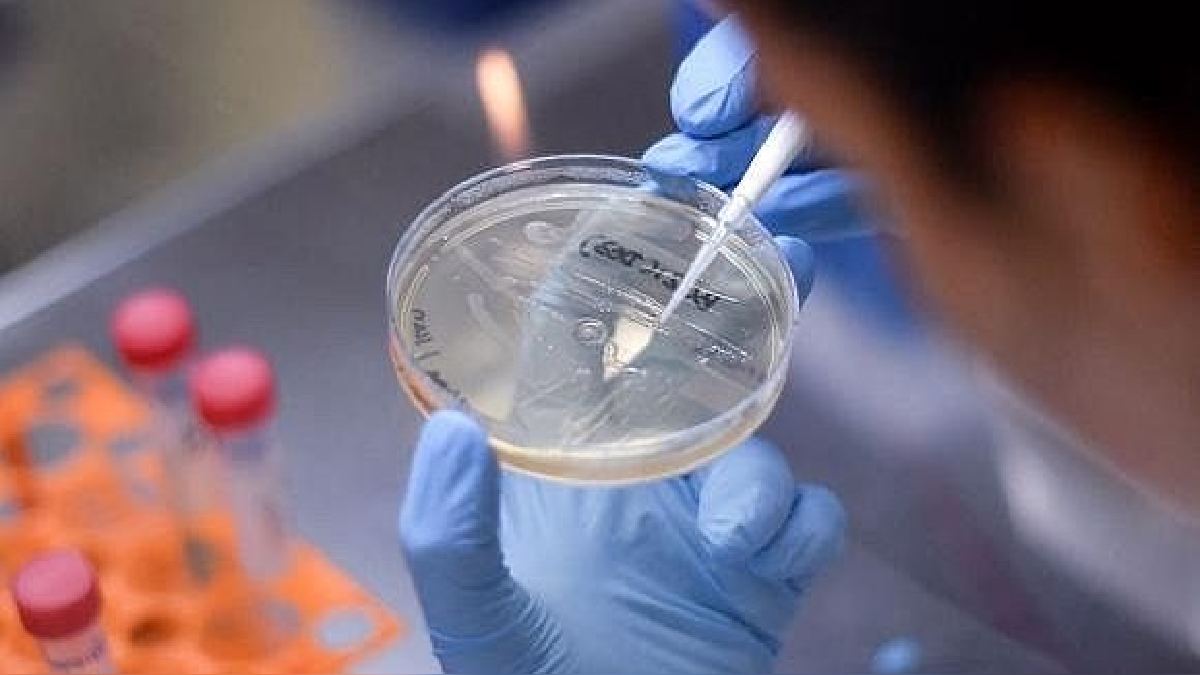

Últimas Noticias

SE INICIA PROGRAMA MUNICIPAL DE SANEAMIENTO FISICO LEGAL "DIGNIDAD"
- Viernes 11 de Agosto del 2023

ATENCIÓN AMIGOS TRANSPORTISTAS
- Viernes 11 de Agosto del 2023

INVITACIÓN AL ANIVERSARIO DE LA ASOCIACIÓN DE FAMILIAS DESPLAZADAS DEL DISTRITO DE INDEPENDENCIA
- Viernes 11 de Agosto del 2023
VARIANTE ERIS, POSIBLE RESPONSABLE DEL REBROTE DE LA COVID-19 A NIVEL MUNDIAL
- Viernes 11 de Agosto del 2023

EL PROYECTO HIDRICO "SANTA CATALINA" SERÀ UNA REALIDAD
- Jueves 10 de Agosto del 2023

NACIÓ EN PERÚ Y HOY ES LA BEBIDA FAVORITA EN EGIPTO : BIG COLA Y SU HISTORIA
- Jueves 10 de Agosto del 2023

MUNICIPALIDAD DE INDEPENDENCIA Y QALI WARMA ENTREGAN YUCA A COLEGIOS DE INICIAL Y PRIMARIA
- Martes 08 de Agosto del 2023

SIMULACRO NACIONAL MULTIPELIGRO 15 DE AGOSTO
- Martes 08 de Agosto del 2023